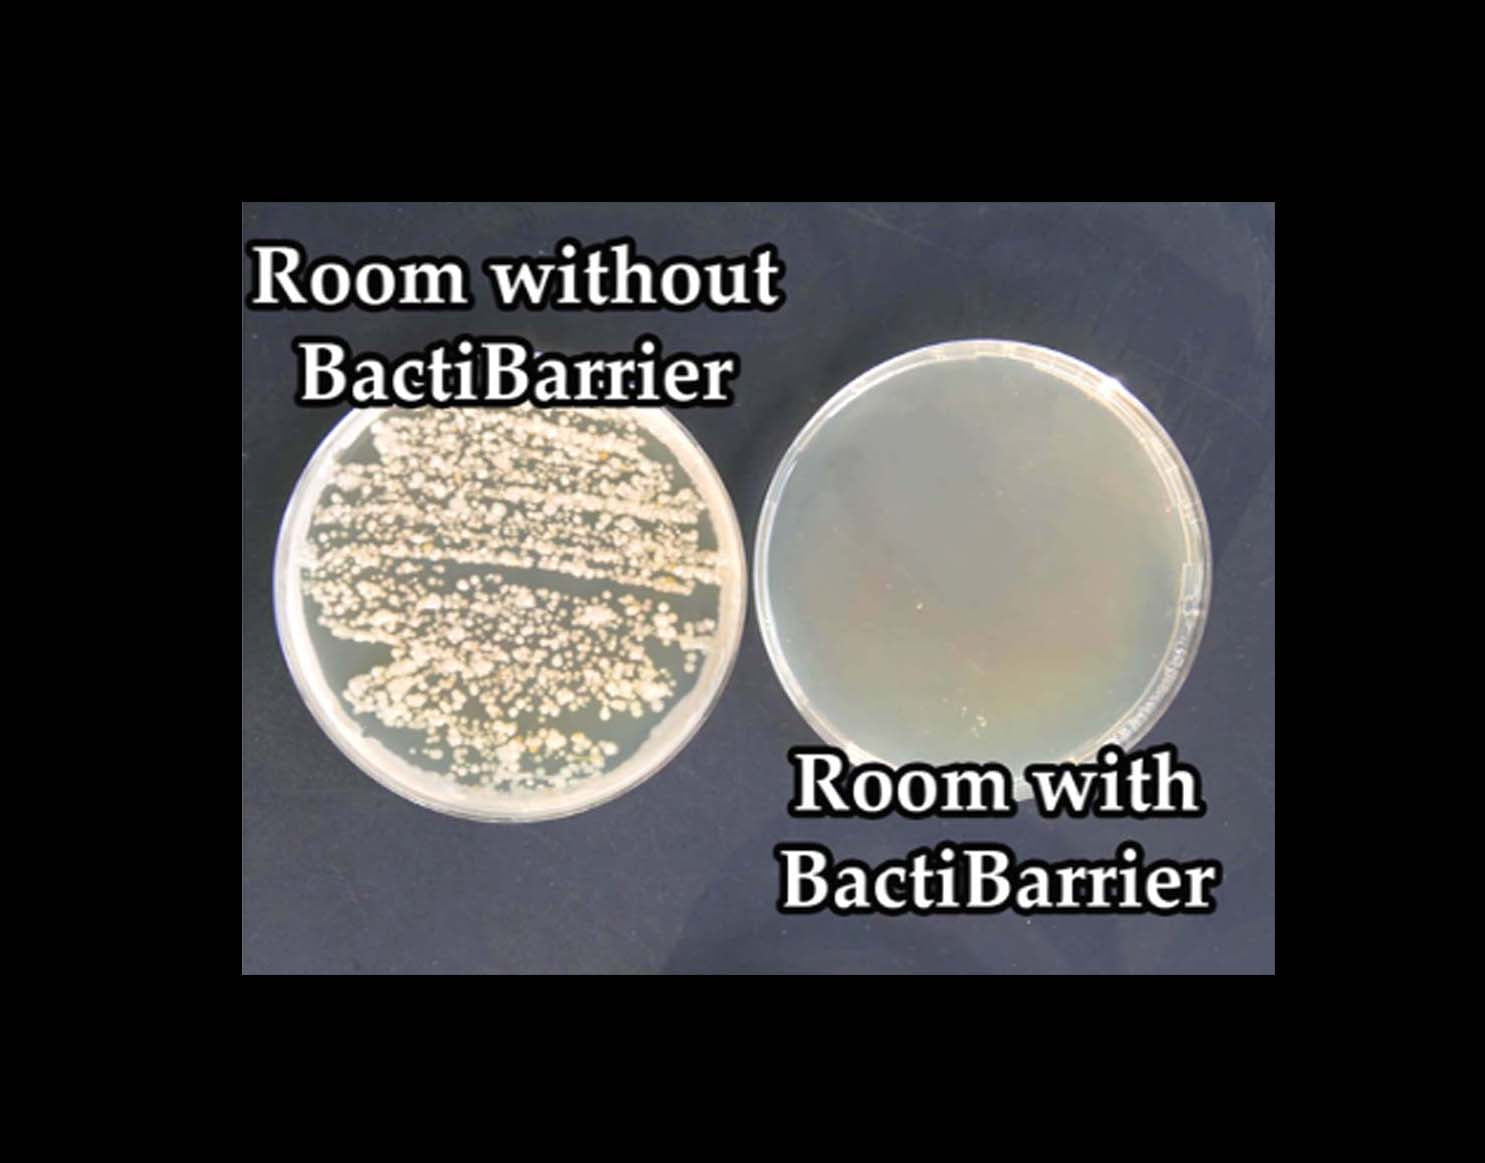

Dioxychlor's Nano-gas technology
A breakthrough in disinfection technology
In an era where cleaner and eco-conscious solutions reign supreme, Dioxychlor's BactiBarrier air technology emerges as the champion of efficiency and effectiveness. Offering an unbeatable combination, it surpasses all others with its unparalleled efficacy, safety, and efficiency, setting a new standard for environmental responsibility.
What's Nano-gas® and how does it function?
Dioxychlor's Air sanitiser
The Battle Against Germs: Unveiling Our Disinfectant's Power
Witness the undeniable effectiveness of our disinfectant as it wages war against germs. Through a potent yet gentle formula, our solution swiftly eliminates harmful microbes, ensuring the air and surfaces are left clean and sanitized without the need for harsh chemicals

Breakthrough chemistry
Reliably Effective:
Our gas particles, tiny yet potent, infiltrate bacterial and viral cell membranes, dismantling them from within before they can react. This unique mechanism ensures that even the most stubborn superbugs remain powerless against our Nano-gas technology, unable to develop resistance.

A sanitizer you can trust
Exceptionally Efficient:
Despite its compact size, our BactiBarrier air sanitiser, measuring less than 15cm in length and 5cm in height, packs a powerful punch. Designed to sanitize the air in a small bedroom effectively, this tiny device utilizes advanced technology to ensure thorough purification, providing you with clean and fresh air without taking up valuable space.

Proven and Trusted:
Our Nano-gas technology, utilized in over 48 states in the USA and over 10 countries in Europe, sets the standard for air purification. Renowned for its effectiveness, it's the go-to choice for ensuring clean and healthy indoor air quality.

Safe and Effective: Protecting People, Pets, and Plants
Our innovative air sanitiser employs advanced technology that ensures safety for all inhabitants, including humans, pets, and plants. Its gentle yet powerful purification process eliminates harmful pathogens while preserving the health and vitality of indoor environments. Notably, our product has been trusted in hospitals across France, including Covid wards, where its efficacy in maintaining clean air has played a crucial role in safeguarding patients and healthcare professionals alike
